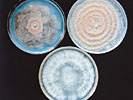

(Koch's Postulates for Proof of Pathogenicity)
Purpose
How do plant pathologists and microbiologists determine what pathogen causes a disease in a plant or animal? A variety of microorganisms (microbes), including bacteria and fungi, can cause disease in plants or animals. In this lab you will learn about Koch’s Postulates, the critical steps used to prove that a particular microbe is the cause of a specific disease in a host organism (plant or animal). This is accomplished by examining the brown fuzzy stuff (a fungal pathogen) growing on a plum and experimentally showing, step by step, whether or not it is the cause of the observed disease.
Background Information
Both plants and animals get sick. Sickness or disease is the harmful disruption of the normal physiology, growth and development of an organism by a causal agent, a pathogen. A pathogen can be a living organism, e.g., fungus, bacterium, nematode, virus, or an abiotic agent, such as air pollution, which causes disease. We recognize that a plant or animal has a disease by looking for signs and symptoms. Signs are the physical presence of the pathogen, or parts of the pathogen, on/in the diseased organism. For example, in the case of a disease caused by a fungus, one might find mycelia or fungal spores growing on the surface of a leaf and/or inside the diseased leaf or other plant tissue. Symptoms are the reaction of the host organism to infection by the pathogen. In diseased plants, symptoms could include wilting, yellowing of the leaves, spots on plant parts, rotted plant parts, and/or dead tissue. If we have a diseased plant and can see signs and symptoms, how do we prove what particular pathogen is causing the disease we observe in that plant? The answer to this question is Koch's Postulates.
Koch's Postulates
Robert Koch (1843-1910) introduced the 19th century scientific community to new and innovative ways for studying bacterial pathogens of animals and humans. His work experimentally confirmed that some microorganisms (microbes) can cause disease in animals and established medical microbiology as a new field of study. He invented a variety of solid culture media for growing bacteria, the plate culture technique for isolating bacteria into pure culture, the slide culture technique, as well as improved methods for looking at bacteria present in diseased tissues with a light microscope. While trying to determine what organism caused anthrax of sheep, Koch devised a sequence of observational and experimental steps to prove to himself that the large bacilli (rod-shaped bacteria) he saw in the blood of animals that had died of anthrax caused this disease. He isolated these bacilli into pure culture and used the culture to inoculate healthy animals, causing them to develop anthrax symptoms and die. He again found the large bacilli in these experimentally inoculated dead animals and was able to re-isolate these bacilli into pure culture.
After his success with anthrax, Koch went on to study tuberculosis, a disease whose causal agent was much more difficult to find. Koch developed new staining techniques that enabled him to see with his microscope the small bacteria in diseased lung tissue taken from people who had died of tuberculosis. He proved that these bacteria caused tuberculosis by following the rigorous criteria he had used studying anthrax. Later in his career, Koch identified the tiny comma-shaped bacterium that causes the deadly disease cholera. Koch's studies of disease etiology led to many improvements in sanitation and public health. Today we still use his criteria, collectively known as Koch’s Postulates, to determine and prove the cause of new diseases.
Simply stated, Koch's Postulates are:
1. The diseased host is observed for signs of the causal organism and symptoms of the disease; the causal organism is shown to be associated with all diseased individuals.
2. The causal organism is isolated into pure culture and described.
3. This pure culture of the suspected pathogen is inoculated into a healthy host and shown to cause the same disease symptoms and signs as originally observed in Step 1.
4. The same causal organism is re-isolated into pure culture from the inoculated diseased host and shown to be identical to the organism described in Step 2.
These criteria are very important because the fastest growing or most abundantly isolated microorganism is not necessarily the cause of the disease symptoms seen. Plants and animals have a wide variety of microorganisms living on their outer surfaces, the majority of which are usually nonpathogenic. Many secondary microorganisms also quickly invade diseased tissue and can cause diagnostic confusion. Koch's postulates help us discern who is the culprit amongst this horde for both plant and animal diseases.
Brown Rot of Stone Fruit
Brown rot is an important disease of stone fruit (apricots, peaches, nectarines, plums, and cherries) worldwide. This disease is caused by three species of fungi
Monilinia fructicola (pronounced Moh-ni-lin-ee-ah fruc-ti-coh-lah),
M. laxa, and
M. fructigena. Unlike single-celled prokaryotic bacteria, fungi are eukaryotic organisms with nuclei and mitochondria. They are comprised of living filaments known as hyphae, or collectively as mycelium. They reproduce by spores which may be sexual or asexual.
If you have ever bought peaches (Figure 1), cherries (Figure 2), or prune plums (Figure 3) that developed soft brown rotten spots followed by an abundant growth of grayish to tan fuzzy tufts, then you are already familiar with the symptoms (effects on the host plant) and signs (evidence of the pathogen), respectively, of this disease.
 |
Figure 1. Brown rot and fungal sporulation on peach fruit. (Courtesy D.F. Ritchie) Click image for an enlarged view. |
 |
Figure 2. Brown rot, fungal sporulation, and mummified cherry fruit. (Courtesy D.F. Ritchie) Click image for an enlarged view. |
 |
Figure 3. Brown rot fungus sporulating on “Stanley” prune plum. (Courtesy D.F. Ritchie)Click image for an enlarged view. |
Fruit rot can occur while the fruit is ripening on the tree, after the fruit is harvested, in storage, in transit on its way to you, the consumer, or later in your own kitchen. However, infection actually can occur much earlier in the growing season. The disease cycle (Figure 4) begins in spring.
 |
Figure 4. Diagram of Disease Cycle of brown Rot of Stone Fruit (Courtesy of Vickie Brewster) Click image for an enlarged view. |
In spring, moisture and warmth trigger growth of the fungus and the production of asexual spores called conidia (pronounced coh-ni-dee-ah) (Figure 5) on the surfaces of cankers (sunken stem lesions) and mummies (Figure 6) hanging in the fruit trees. Mummies are the dried up, shriveled fruits that were infected and colonized by the brown rot fungus(-i) during the previous growing season. In the case of
M. fructicola, sexual spores, called ascospores, also may also be produced in cup-shaped fruiting bodies called apothecia (pronounced a-poh-thee-see-ah) (Figure 7) on mummies partially buried in the soil of the orchard floor. Ascospores (Figure 8) are forcibly ejected from the asci (pronounced a-sigh) (spore sacs) under the right weather conditions. However, the sexual stage does not occur very often in orchards, so most infections begin from conidia.
During blossom time, conidia and/or ascospores are splashed, blown, or carried by insects to the surfaces of flowers and new twigs. The spores germinate and infect the flowers and twigs causing them to turn brown and die, a condition known as blight (Figure 9). As these infected parts die back, twig cankers form (Figure 10). Later in the season, sporulation of the fungus on twig cankers provides inoculum to infect the ripening fruit. Fruit become more susceptible to infection by the fungus as they ripen. Rain during the ripening period and during harvest, as well as wounds caused by insects, also favor the rapid spread of this disease. Infected fruit dry out and turn into mummies, often still hanging on the tree. Mummies and cankers serve as overwintering structures, i.e., ways for the fungus to survive until the next growing season when the disease cycle starts over again.
 |
Figure 9. Twig blight and blighted blossoms.
(Courtesy D.F. Ritchie) Click image for an
enlarged view. |
 |
Figure 10. Blighted blossom, twig canker, gummy exudate, and tufts of conidia. (Courtesy D.F. Ritchie) Click image for an enlarged view. |
Sanitation, fungicides, and careful harvesting procedures are used to control this disease. In some parts of the country, control of certain insects is also necessary. Removal of dropped fruit and mummies from the orchard floor and trees reduces sources of overwintering inoculum. Fungicides are applied at appropriate times during the growing season. After harvest, fruit may be dipped in fungicide to prevent them from rotting in storage and on their way to market. Careful handling to prevent injury to the fruit and quickly cooling the picked fruit also help reduce the amount of post-harvest brown rot.
In this lab you will be looking at the fruit rot stage (Figures 1 through 3) of the disease. Brown rot appears first as small brown spots on the surface of fruit. These brown spots rapidly enlarge to decay the whole fruit. Masses of ash-gray to tan spores and mycelia are produced on the decayed area (Figure 11). Cultures of the fungus are easily grown by transferring a loopful of conidia from the sporulating mass on a diseased fruit to a plate of potato dextrose agar, but a more reliable means of isolating pure cultures is described in the exercise. Figure 12 shows plate cultures of the different species of
Monilinia. Conidia are produced in chains on tufts of mycelia called sporodochia (pronounced spore-oh-doh-key-ah). When you look at a chain of conidia under the microscope, it will look like a string of colorless, lemon-shaped beads. (Figure 5).
 |
Figure 11. Brown rot symptoms prior to fungal sporulation (left) and peach fruit with abundant sporulation (right). (Courtesy D.F. Ritchie) Click image for an enlarged view. |
|
Figure 12. Morphologies of cultures of
Monilinia laxa (left),
M. fructicola (right), and
M. fructigena (bottom). (Courtesy APS Press, Compendium of Stone Fruit Diseases) Click image for an enlarged view. |
If you would like to learn more about this disease, see the Plant Disease Lesson "Brown rot of stone fruit" by D. F. Ritchie in the Introductory section of the APS Education Center.
